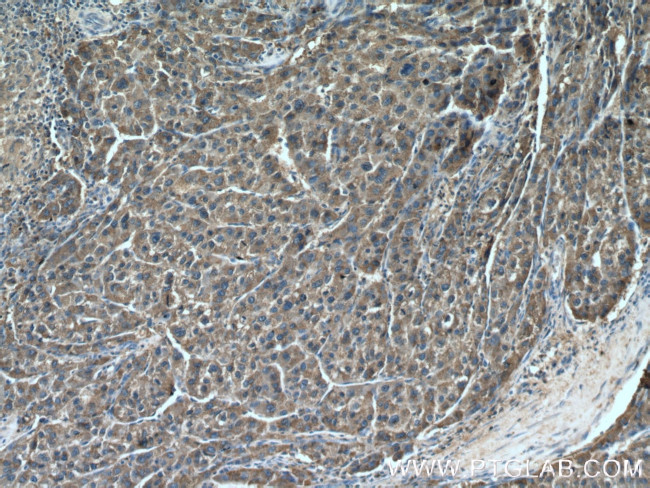
DUS4L Antibody in Immunohistochemistry (Paraffin) (IHC (P))

Search
Proteintech
DUS4L Polyclonal Antibody
{{$productOrderCtrl.translations['antibody.pdp.commerceCard.promotion.promotions']}}
{{$productOrderCtrl.translations['antibody.pdp.commerceCard.promotion.viewpromo']}}
{{$productOrderCtrl.translations['antibody.pdp.commerceCard.promotion.promocode']}}: {{promo.promoCode}} {{promo.promoTitle}} {{promo.promoDescription}}. {{$productOrderCtrl.translations['antibody.pdp.commerceCard.promotion.learnmore']}}
产品信息
21870-1-AP
种属反应
宿主/亚型
分类
类型
抗原
偶联物
形式
浓度
规格
纯化类型
保存液
内含物
保存条件
运输条件
产品详细信息
This antibody recognize the C-terminal of DUS4L.
Immunogen sequence: AMAEGYGAC LINKPELVQD MVKQVRNQVE TPGFSVSIKI RIHDDLKRTV DLCQKAEATG VSWITVHGRT AEERHQPVHY DSIKIIKENM SIPVIANGDI RSLKEAENVW RITGTDGVMV ARGLLANPAM FAGYEETPLK CIWDWVDIAL ELGTPYMCFH QHLMYMMEKI TSRQEKRVFN ALSSTSAIID YLTDHYGI (121-317 aa encoded by BC111774)
靶标信息
Catalyzes the synthesis of dihydrouridine, a modified base found in the D-loop of most tRNAs.
仅用于科研。不用于诊断过程。未经明确授权不得转售。
篇参考文献 (0)
生物信息学
蛋白别名: pp35; protein similar to E.coli yhdg and R. capsulatus nifR3; tRNA-dihydrouridine synthase 4-like; tRNA-dihydrouridine(20a/20b) synthase [NAD(P)+]-like; unnamed protein product
基因别名: 2310069P03Rik; 2700089B10Rik; AI482040; DUS4; DUS4L; PP35
UniProt ID: (Human) O95620, (Mouse) Q32M08
Entrez Gene ID: (Human) 11062, (Mouse) 71916